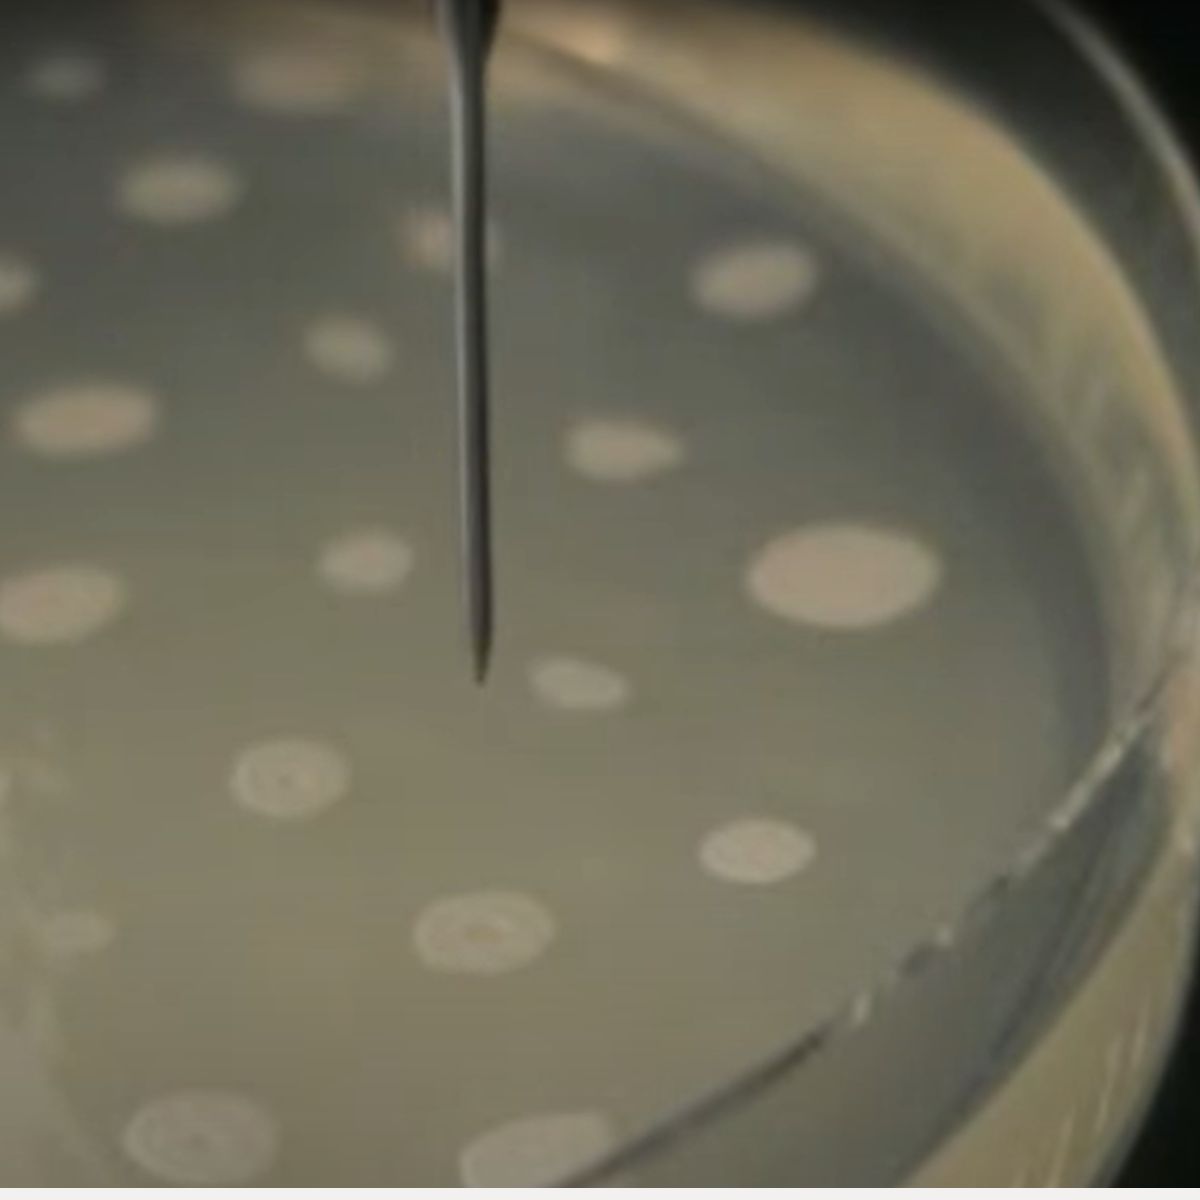
TOPAZ CP 全自動コロニーピッカー

説明
TOPAZ CPは培養菌体や微生物コロニーの自動ピッキングを可能にする、100%国産の自動装置です。高解像度カメラで取得された鮮明な画像から、培養コロニーを画像認識し、専用の解析アルゴリズムを用いて、様々な菌やアプリケーションに対応したセレクションを実現します。
認識したコロニーはコンタミネーション対策された専用ピッキング針で高精度に移植が行われます。最適構成を選択できる製品バリエーションで、小規模スクリーニングから HTS まで幅広く対応します。
- 約2100万画素、高精細カメラによる4×6分割撮影で微小コロニーの認識抽出が可能です。
- 1000コロニー/時間の高速処理を実現します。
- 中央の移植元ステージは、下方からの透過照明、上方からの落射照明が利用できます。
- 移植元ステージの左右には、SBS規格のマイクロプレートをセットできる2つの移植先ステージがあります。
- 独自の針先自動補正機構で針先端の位置補正を行うことで、より確実なコロニーピッキングができます。
- 自動針交換機構により、指定条件での自動でのピッキング針交換が可能です。
- ピッキング針は、本体内に装備されたエタノール槽でのブラッシング、リンス、ヒーターを用いた乾熱滅菌の、三段構えのコンタミネーション対策がなされています。
- 機器停止時にチャンバー内を殺菌するタイマー機能付UV灯を装備しています
- HEPAフィルターユニット(オプション)による清浄空気環境での処理が可能です。
- 遠隔制御機能(オプション)を使えば、他のロボットアーム等と連携した自動化システムを構築できます。
| モデル | TCP1 |
| 対応容器(移植元) |
φ90,ペトリディッシュ オムニトレイ マイクロプレート(オプション) |
| 対応容器(移植先) |
96Well、384Wellマイクロプレート (シャロー、ディープ、PCRプレート) オムニトレイ |
| カメラ | カラーCMOS 実効9~16MPixel |
| 位置精度 | 30um以下 |
| ピッキング精度 | 約0.5mm(サンプル条件による) |
| 最大処理数 | 1000 pick / hour |
| ピンヘッド数 | 2 |
| 電源 | AC100V 50/60Hz |
| 外寸法 | 本体:W650×D500×H650 mm 制御盤:W700×D200×H600 mm 架台設置時:W750×D670×H1435 mm |
| 重量 | 約65kg(本体)/ 約40kg(制御盤) 約45kg(架台) |